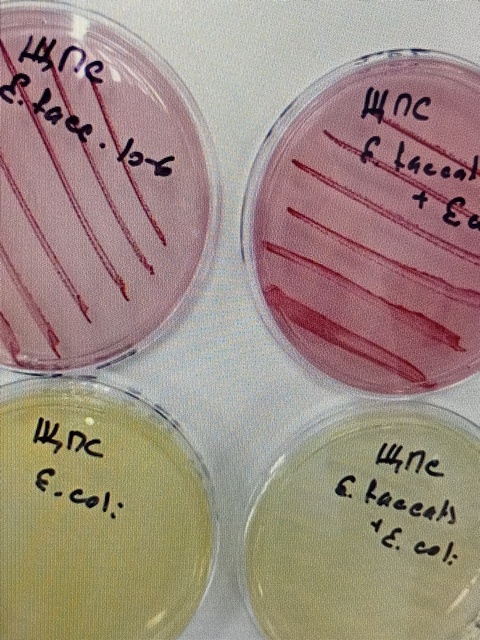

23. ГБУ Брянской области "Дубровская зональная ветеринарная лаборатория"
Директор - Ивашин Владимир Николаевич
Адрес: 242750, Брянская обл., Дубровский р-н, пгт. Дубровка, ул. Ленина, 2
тел. (48332) 9-11-49
e-mail: Этот адрес электронной почты защищен от спам-ботов. У вас должен быть включен JavaScript для просмотра.
Официальная страница в социальной сети: Вконтакте
Эстроз овец

Эстроз — заболевание овец, которое возникает из-за заражения личинками носополостного овода. Болезнь опасна высоким риском распространения инфекции, воспалением носовой полости и даже оболочки головного мозга, что ведёт к снижению продуктивности и гибели поголовья.
Некоторые симптомы эстроза у овец:
Беспокойное поведение. При появлении оводов овцы сбиваются в кучу, пытаются укрыться и активно трясут головами.
Раздражение и зуд. Овцы трутся головой о предметы, пытаясь избавиться от дискомфорта.
Архив испытательной лаборатории

Согласно Приказа Минэкономразвития РФ от 26.10.2020 N 707 испытательная лаборатория должна иметь систему хранения и архивирования документов, в том числе правила хранения и архивирования, предусматривающие хранение на бумажных носителях и (или) в форме электронных документов, подписанных усиленной квалифицированной подписью, по месту (местам) осуществления деятельности в области аккредитации архива документов, в том числе документов, представленных в лабораторию заявителями для проведения исследований (испытаний) и измерений, в течение трех лет со дня выдачи соответствующего документа о результатах исследований (испытаний) и измерений, или принятия решений об отказе в его выдаче; правила систематизации и ведения архива документов, в том числе условия передачи документов в архив, условия выдачи документов из архива, сроки хранения в архиве документов (групп документов), правила регистрации документов, поступающих в архив, условия хранения документов.
Куриный клещ

Куриный клещ - кровососущий временный эктопаразит. Тело D. gallinae грушевидное, беловатого или красноватого цвета; 0,7—0,75 мм длины и 0,4 мм ширины. Жизненный цикл включает 5 фаз: яйцо, личинка, протонимфа, дейтонимфа и имаго. Из отложенных самками яиц через 50—120 часов выходят личинки, которые не питаются. Через 24—30 часов малоподвижная личинка превращается в протонимфу. Стадии протонимфы и дейтонимфы поглощают кровь хозяина и активно передвигаются. Дейтонимфы превращаются во взрослых самцов и самок. Самка откладывает до 20 яиц, число которых зависит от количества высосанной крови.
Контроль питательных сред
Различные серии сред, приготовленные даже по одному и тому же рецепту, могут различаться по питательной ценности или другим свойствам. В связи с этим питательные среды, как производственные, так и приготовленные в лаборатории, должны подвергаться внутрилабораторному контролю.
Для проведения внутрилабораторного контроля качества питательных сред можно использовать следующие нормативные документы:
ГОСТ ISO 11133-2016 Микробиология пищевых продуктов кормов для животных и воды Приготовление, производство, хранение и определение рабочих характеристик питательных сред.
Неоаскаридоз телят

Неоаскаридоз у крупного рогатого скота — это инфекционное заболевание, вызываемое нематодами рода Neoascaris vitulorum, которое поражает в основном телят в возрасте от двух недель до четырех месяцев. Эти паразиты локализуются в тонком кишечнике и могут вызывать серьезные расстройства пищеварения.
Возбудитель:
Neoascaris vitulorum относится к семейству Anisakidae и подотряду Ascaridata.
Это крупные нематоды длиной от 11 до 30 см.
Характерный морфологический признак — расширение (желудочек) пищевода в месте перехода его в кишечник.
Яйца неоаскарид имеют диаметр 0,07—0,09 мм и имеют ячеистую оболочку.
Лейкоз крупного рогатого скота

Лейкоз крупного рогатого скота относится к числу наиболее распространенных хронических инфекционных болезней сельскохозяйственных животных. В развитии заболевания различают бессимптомную, гематологическую и клиническую стадии. Диагностические исследования на лейкоз проводят серологическими, молекулярно-биологическими, гематологическим, клиническим и патоморфологическими методами. Постоянным и характерным признаком инфицированности животных является наличие антител к антигену ВЛКРС, следовательно, одним из важных моментов в диагностике является выявление инфицированных животных при помощи различных серологических методов.
Проверка качества кормов, заготовленных для зимовки скота

Важной составляющей удачной зимовки скота, конечно же, является наличие достаточного количества и хорошего качества кормов. Качество кормов для зимовки скота очень важно, так как зимой животные не дополучают необходимое количество питательных и витаминно-минеральных веществ, которые летом они могут получить при поедании зелёной травы. Рацион в зимний период должен состоять из запасённых кормов в летне-осенний период: сена, соломы, силоса, сенажа и комбикормов.
Подробнее: Проверка качества кормов, заготовленных для зимовки скота
Учения по гриппу

17 июня 2025 года в Дубровском районе на территории ГБУ Брянской области «Дубровская межрайонная ветеринарная станция по борьбе с болезнями животных» прошла учебная тренировка на тему: «Ликвидация условного очага высокопатогенного гриппа птиц».




























